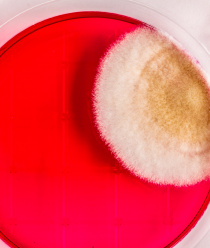
НПО Альтернатива

О компании
Научно-производственное объединение «Альтернатива» занимается разработкой и продвижением комплексных пищевых добавок и антисептиков. Наши препараты успешно борются с широким спектром патогенных микроорганизмов - основной причиной порчи пищевой продукции.
Наша целевая аудитория - производители кондитерских и хлебобулочных изделий, молока и кисломолочных продуктов, пива и безалкогольных напитков, мясной и рыбной продукции, масел и жиров, кулинарии. Мы помогаем сохранить качество и продлить срок годности продукта.
«Петритест» – решение проблемы везде, где нужна чистота и контроль! Петритест - это российский аналог таких тест-систем, как Дипслайд, Petrifilm, RIDA COUNT, Oxoid, Orion Diagnostica, Schülke & Mayr, Merck Millipore, Singlepath, Duopath, MVP ICON, HY-RiSE, Envirocheck Dip Slides, MC-Media Pads , Sampler, HYCON Contact SlidesQuant.